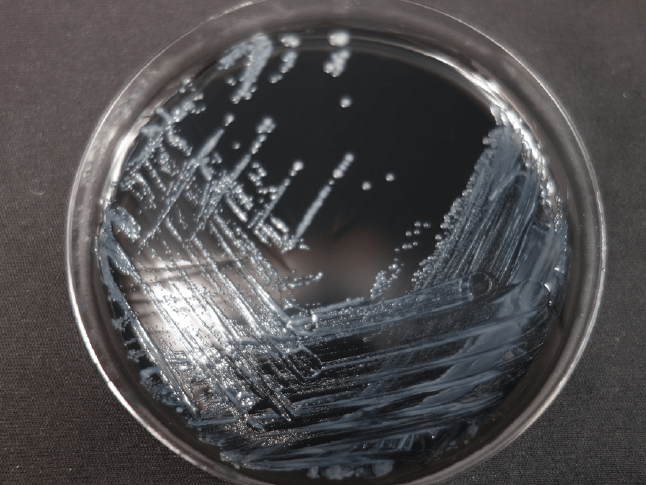

Legionella pneumophila 生长于含半胱氨酸之活性碳酵母萃取物培养基
有关退伍军人菌生物特性
退伍军人菌属于 Legionellaceae 科 Genus Legionella 属,具近 48 种以上的菌属与 70 种以上的血清型 (serogroup),其中嗜肺性退伍军人菌 (L. pneumophila)最常被分离,可分为14 种血清型,血清型第一型 (L. pneumophila serogroup 1) 高达 70% 的致病率。
环境耐受性强,于水环境 0 ~ 63℃ 及 pH 5.0 ~ 8.5 间皆可存活,32 ~ 45℃ 为最佳繁殖温度,广泛存在于一般水体中,而自来水供水系统,由于水质环境适合其生存,且易因管线设计或管理不当致使管线内产生生物膜,提供了退伍军人菌繁殖的机会;其他易潜藏于工业冷却水系统、中央空调系统、喷泉、游泳池、SPA 水疗、水塔、各种冷却供水系统与冷气机当中。
| 适存温度 | 5 ~ 65 ℃ |
| 最适温度 | 35 ~ 45 ℃ |
| 环境 pH 值 | 5.5 ~ 9.5 |
退伍军人菌可抵抗原虫细胞之内部溶解机制,又自然宿主为阿米巴原虫,提供退伍军人菌良好的繁殖空间以躲避杀菌剂作用,并产生更具毒性之退伍军人菌,如 Hartmannella、Acant bamoeba 及 Naegleria spp.,因此当寄生在此原虫体内会较具抗药性,不易被歼灭。

退伍军人症与庞提亚克热
退伍军人症候群为急性细菌性感染,感染后会引起的两种常见流行病,分别为退伍军人病(Legionnaires’ Disease)& 庞提亚克热(Pontiac Fever),其中退伍军人病潜伏期为 2 ~ 10 天,通常是 5 ~ 6 天。庞提亚克热潜伏期为 2 ~ 4 天。在众多退伍军人菌属中只有 L. peumophila、L. micdadei、L. feelei、L. anisa 四种会造成庞提亚克热,此两种疾病刚开始时具有下列共同的症状:厌食、身体不适、全身不适、咳嗽、发冷,其次为呼吸困难、肌肉酸痛、头痛、胸痛、腹痛、咳浓痰等。体温通常高达 39.0 ~ 40.5 ℃。
| 退伍军人病 | 庞提亚克热 | |
|---|---|---|
| 潜伏期 | 一般为 2~ 10 天 通常为 5 ~ 6 天 | 2~ 4 天 |
| 临床表现 | 非典型肺炎 | 如同感冒症状,不会出现肺炎 |
| 好发对象 | 年长者或免疫机能障碍者 | 健康年轻人 |
| 流行病学特征 | 低治病率 : 0.2 ~ 7.0 % 高致死率 : 一般人约 15 % 免疫机能障碍者约 : 50 % | 超过 90 % 感染率 |
| 治疗方式 | 藉由抗生素治疗 | 不需特别治疗即可痊愈 |

水塔系统清洗及消毒方式,防治退伍军人菌
退伍军人菌容易出现在任何水源中,并随着水源中的生物膜长期存在,难以根除,因此如何有效降低退伍军人菌孳生是预防感染的重要议题。根据主管机关过往的统计与调查中指出,定期消毒与清洗是预防退伍军人菌最有效的方法。
1. 加热消毒法
文献指出 (Will et al., 2003),加热会破坏菌体重要的酵素,进而使菌体死亡。在 50 ℃ 条件下,可于 2 小时内杀灭约 9 成的退伍军人菌;在 60 ℃ 条件下可于 2 分钟内杀灭约 9 成的退伍军人菌。
★各温度条件下退伍军人菌的生长情况 :

2. 加氯消毒法
氯离子与菌体接触后会发生氧化作用,进而破坏细胞结构,使菌体死亡。
3. 铜银离子消毒法
铜、银离子会吸附于菌体细胞膜上,造成菌体溶解死亡。
4. 臭氧消毒法
臭氧阴离子会破坏菌体中的 DNA,使菌体死亡。
5. 紫外线消毒法
紫外线会改变菌体细胞膜的通透性,进而导致菌体死亡。
冷却水塔之清洗及消毒方式
(1) 维护原则
• 停止使用超过 1 个月 (医院冷却水塔则为停止超过 5 天) 进行清洗和消毒。
• 每季或每半年进行一次排水去污、清洗和消毒。
• 定期使用杀菌剂、抗锈剂和生物分散剂等,控制水中有机体产生和降低生物膜。
• 定期进行微生物检测。
(2) 清洗及消毒步骤
|
|
Step 1使用含有生物分散剂和 5 mg/L 余氯浓度的水进行循环约六小时(若水体 pH 值大于 8,则需提高余氯浓度至 5 ~ 20 mg/L) |
|
|
|
Step 2排光水塔中的水 |
|
|
|
Step 3以人工清洗冷却水塔与输水系统装置 |
|
|
|
Step 4重新注入干净水,并以含氯和生物分散剂的水重新消毒 |
|
|
|
Step 5在送风关闭状态下运作六小时,并保持余氯浓度在 5 ~ 15 mg/L |
|
|
|
Step 6排光水塔中的水 |
|
|
|
Step 7再次冲洗后,重新注入清水并添加适当的杀菌剂 |
|
|
|
Step 8完成清洗,重新运转 |
水塔消毒清洗方式比较表
| 消毒方式 | 灭菌条件 | 优点 | 缺点 |
|---|---|---|---|
| 加热法 | 加热温度至 70 ℃ 以上 |
|
|
| 加氯法 | 水中余氯 1 ~ 3 mg/L |
|
|
| 加铜银 离子法 | 水中离子浓度 : 铜离子:0.2 ~ 0.4 mg/L 银离子:0.02~0.04 mg/L |
|
|
| 臭氧法 | 水中臭氧浓度: 0.1 ~ 0.5 mg/L 或 0.8 ~ 1.5 g/m3 |
|
|
| 紫外线法 | 照射波长 254 nm |
|
|
任何实验室皆可从事退伍军人菌的检验吗 ?
并非所有实验室皆可从事退伍军人菌的检验。退伍军人菌可藉由空气传播,因此若不具 P2 等级安全实验室,且不具有相关保护措施与生物安全柜(biosafety cabinet),会对整个环境,包含实验室、办公室与公共区域造成立即性的危害。
退伍军人菌检测专家
在台美检验所提供的众多环境检测项目中,以退伍军人菌检测最为著名,退伍军人症发作率1 ~ 5 %,死亡率可高达20 % ,若患者免疫能力有障碍,死亡率会更高,台美检验是国内最早取得退伍军人菌TAF 认证的委托检验机构,具有多年的丰富经验,是检测退伍军人菌的专家,并具以下服务特点:
设备规格:P2 plus 等级生物安全实验室及生物安全柜
检验认可:财团法人全国认证基金会(TAF)认证
检验能力:分离力高,退伍军人菌阳性分离率达到 15% 以上
台美退伍军人菌服务特色:
1. 若分离出退伍军人菌,可免费保留该菌种
2. 提供消毒方法及专业咨询服务
3. 专员采检,免除您采检错误、使用污染的容器以及邮寄检体困扰







